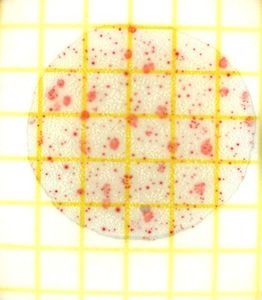
Bakterien: Behandlung ohne Antibiotika (Foto: pixelio.de, Sebastian Karkus)

Chlamydien: Gentherapie statt Antibiotika
Nanotechnologie verhindert Ausbreitung der Krankheit - Eine Dosis hat Erfolgsrate von 65 Prozent
![]() |
Bakterien: Behandlung ohne Antibiotika (Foto: pixelio.de, Sebastian Karkus) |
Waterloo (pte001/07.02.2019/06:00) Forscher der University of Waterloo http://uwaterloo.ca haben eine neue Möglichkeit zur Prävention und Behandlung von Chlamydien-Infektionen entwickelt. Sie gelten weltweit als die häufigste sexuell übertragene bakterielle Infektion. Der neue Ansatz basiert nicht auf Antibiotika, sondern auf einer Gentherapie, die mittels Nanotechnologie zum Einsatz kommt. Mit einer einzelnen Dosis konnte bei der Prävention eine Erfolgsrate von 65 Prozent erreicht werden.
Unfruchtbarkeit vermeiden
Laut Forschungsleiter Emmanuel Hon nehmen die Resistenzen gegen Antibiotika weiter zu, viele Patienten könnten daher die Erfahrung machen, dass ihre Infektion auf herkömmlichem Weg nicht mehr zu behandeln ist. "Wird eine Infektion nicht behandelt oder muss die Behandlung über einen längeren Zeitraum durchgeführt werden, kann es zu Unfruchtbarkeit und anderen gesundheitlichen Problemen kommen. Daher ist es wichtig, neue Behandlungsansätze zu finden.
"Da die U.S Food and Drug Administration kürzlich das erste siRNA-Medikament zugelassen hat, hoffen wir, dass diese Art von Forschung in Zukunft allgemein zugänglich sein wird", so Hon. Die neue Therapie zielt auf die Infektion ab, indem der Großteil der Bakterien daran gehindert wird, in die Zellen des Genitaltrakts einzudringen sowie auf die Zerstörung aller Bakterien, die in der Lage sind, eine Zellwand zu durchdringen. Dafür nutzt das Team eine siRNA, die auf das Gen PDGFR-beta in den weiblichen Geschlechtsorganen abzielt. Dieses Gen spielt bei einem Protein eine entscheidende Rolle, das sich an die Chlamydienbakterien anbindet.
Gegen Produktion von Protein
"Durch das Abzielen auf PDGFR-beta konnten wir die Produktion des Proteins verhindern, das die Chlamydien nutzt, um in die Hautzellen des Genitaltrakts einzudringen. In der Folge hat eine auftretende Infektion weniger mögliche Ziele und tritt weniger wahrscheinlich auf", sagt Hon. Können sich Chlamydienbakterien an Zellen anbinden und in sie eindringen, dann ist die Behandlung mittels Nanomedizin darauf ausgerichtet, eine Autophagie auszulösen.
Dabei wird den infizierten Hautzellen ermöglicht, eine Blase rund um das Bakterium zu bilden und es zu zerstören. Allein ist es der siRNA nicht möglich, in die Hautzellen einzudringen, die Expression von PDGFR-beta zu verringern und eine Anbindung der Chlamydien zu verhindern. Die neue Gentherapie nutzt daher ein Nanopartikel, das es der siRNA ermöglicht, in die Zellen einzudringen und in der Folge verhindert, dass sich die Krankheit ausbreitet. Die Forschungsergebnisse wurden in "Scientific Reports" veröffentlicht.
(Ende)| Aussender: | pressetext.redaktion |
| Ansprechpartner: | Moritz Bergmann |
| Tel.: | +43-1-81140-300 |
| E-Mail: | bergmann@pressetext.com |
| Website: | www.pressetext.com |